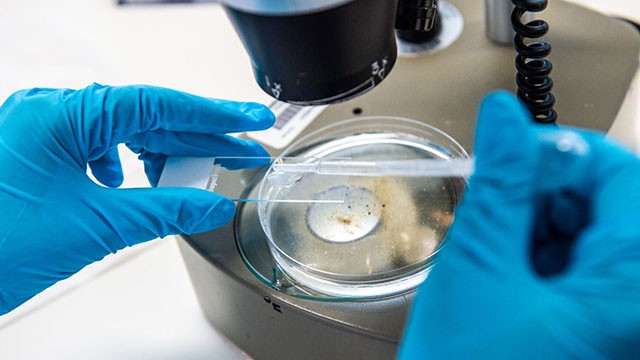

One Health, One Medicine
We understand that human health is closely linked to animals, plants and our shared environment. To improve our health and that of animals, we’ve implemented a ‘One Health, One Medicine’ approach, bringing together expertise from a broad range of multidisciplinary areas.
Our vision
Our One Health, One Medicine vision is to create and lead globally connected health research and education, and to share innovation and knowledge, to sustainably improve the wellbeing of humans and animals.
Our One Health, One Medicine approach
Our interactions with animals, plants and our wider environment have drastically changed over the last century. For example:
Population growth: The number of human beings on the planet are increasing and we’re coming into closer proximity to animals and our shared environments.
Climate change and land use: Changes in weather and environmental disruption, including deforestation and farming, are changing the landscape of our planet.
Movement: Borders between countries are more open than ever before, with increased trade and international travel.
All these factors and many more, provide more opportunities for disease to spread. Our One Health, One Medicine approach takes into consideration all the factors involved, to achieve the best health outcomes for all. These include:
- Agricultural production and land use
- Antimicrobial resistance
- Biodiversity and climate change
- Disease surveillance, prevention and response of chronic and infectious diseases
- Environmental health
- Food safety and food security
- Global trade, commerce and security
- Mental health
- Occupational health
- Public policy and regulation
- Water safety and security
- Wellbeing of humans, animals and ecosystems.
Explore One Health, One Medicine at Surrey
With the emergence of Covid-19, the importance of One Health, One Medicine research has never been clearer. International and interdisciplinary collaboration is imperative to predict, prevent and respond to such disease threats.